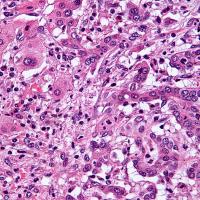

- redazione
- Salute
Articolo
È svolta nell'uso del tamoxifene - un farmaco utilizzato dopo l'intervento chirurgico nelle donne che hanno avuto un tumore al seno intraepiteliale, pari a circa il 20% di tutti i tumori alla mammella - per ridurre il rischio di recidive: è efficace anche a basse dosi e con effetti collaterali molto ridotti.
Lo dimostra uno studio presentato al... Continua
Articolo
È proprio vero che i grani antichi sono meno tossici dei moderni per i celiaci? E che hanno livelli più alti di carboidrati potenzialmente prebiotici (amido resistente e fibre)? L’incremento dei casi di celiachia può essere, quindi, una conseguenza del miglioramento genetico condotto nel secolo scorso?
Lo studio Per dare risposte scientificamente... Continua
Articolo
È nato al Bambino Gesù l’Ambulatorio per la prevenzione e la diagnosi precoce delle allergie. È rivolto ai neonati entro il 28° giorno di vita ad alto rischio allergico, vale a dire i bambini con almeno un parente di primo grado (mamma, papà o fratellino) affetti da allergia. È attivo presso la sede di Roma - San Paolo e svolge attività di... Continua
Articolo
Mangiare troppa carne rossa fa male al cuore perché provoca l'aumento di concentrazione di una sostanza pericolosa chiamata TMAO (trimetilammina-N-ossido).
Lo rivela un esperimento i cui risultati sono stati resi noti dall'European Heart Journal, condotto con un gruppo di volontari presso la Cleveland Clinic.
Lo studio prende le mosse da anni di... Continua
Articolo
Asimmetrico, con bordi irregolari e in rapida modificazione: sono queste le caratteristiche di un neo sospetto, ma osservarle a occhio nudo non è sufficiente a capire se possa trattarsi di un tumore della pelle. Così facendo, infatti, uno su dieci può non venir individuato.
A mettere in guardia è una revisione di 104 studi, pubblicata sulla... Continua
Articolo
Grazie a uno studio condotto presso la Fondazione Policlinico Universitario Agostino Gemelli IRCCS di Roma si è scoperto che nel 75% dei casi di “sindrome di Brugada”, una rara malattia che colpisce il cuore, alla base delle aritmie cardiache tipiche della patologia c’è un’anomalia del muscolo cardiaco stesso e uno stato infiammatorio anomalo. La... Continua
Articolo
Cibo buono e di qualità. È questo binomio che da sempre rappresenta l’Italia a tavola, con la sua inconfondibile cucina ricca di varietà e tradizioni gastronomiche regionali che hanno saputo, e sanno tuttora, conquistare i palati più esigenti dovunque nel mondo. Se pasta e pizza non potranno essere mai davvero sostituiti nella nostra alimentazione... Continua
Articolo
Le fratture da fragilità sono una vera e propria emergenza nel nostro Paese, ma siamo ancora ben lontani dalla sua risoluzione: risorse e strumentisono ancora troppo limitati e soprattutto mancano delle linee guida nazionali che siano in grado di indirizzare l’operato dei medici con diretta ricaduta sulla salute dei pazienti, sia per quanto... Continua
Articolo
Si apre la strada a una nuova strategia di cura per il colangiocarcinoma non operabile e non più responsivo alla chemioterapia grazie a derazantinib, un inibitore selettivo di FGFR2. Lo evidenzia lo studio condotto su pazienti afferenti a importanti Cancer Centers europei e americani guidati dall’Istituto Nazionale dei Tumori di Milano e... Continua
Articolo
Scoperta la firma molecolare comune a molte forme di tumore: è scritta nel DNA che le cellule tumorali liberano nell'organismo quando muoiono. La sua identificazione renderà la diagnosi precoce più rapida. È quanto emerge dallo studio pubblicato sulla rivista Nature Communications da un gruppo dell'Università del Queensland (Australia), coordinato... Continua
Categoria
autore
- (-) Remove redazione filter redazione